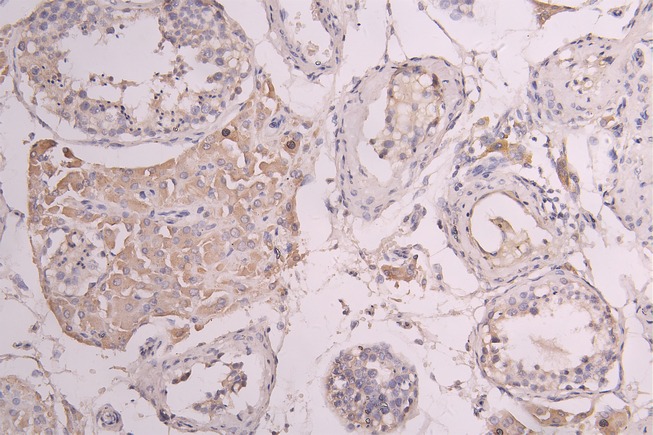

CSF3R Recombinant Monoclonal Antibody
-
中文名稱:CSF3R重組抗體
-
貨號:CSB-RA860321MA1HU
-
規格:¥1320
-
圖片:
-
IHC image of CSB-RA860321MA1HU diluted at 1:100 and staining in paraffin-embedded human testis tissue performed on a Leica BondTM system. After dewaxing and hydration, antigen retrieval was mediated by high pressure in a citrate buffer (pH 6.0). Section was blocked with 10% normal goat serum 30min at RT. Then primary antibody (1% BSA) was incubated at 4°C overnight. The primary is detected by a Goat anti-human polymer IgG labeled by HRP and visualized using 0.05% DAB.
-
IHC image of CSB-RA860321MA1HU diluted at 1:100 and staining in paraffin-embedded human cervical cancer performed on a Leica BondTM system. After dewaxing and hydration, antigen retrieval was mediated by high pressure in a citrate buffer (pH 6.0). Section was blocked with 10% normal goat serum 30min at RT. Then primary antibody (1% BSA) was incubated at 4°C overnight. The primary is detected by a Goat anti-human polymer IgG labeled by HRP and visualized using 0.05% DAB.
-
-
其他:
產品詳情
-
產品描述:CSF3R重組單克隆抗體(CUSABIO貨號:CSB-RA860321MA1HU)是一款針對粒細胞集落刺激因子受體(CSF3R)研發的高特異性抗體。CSF3R是調控中性粒細胞增殖、分化及存活的關鍵跨膜受體,其功能異常與先天性中性粒細胞減少癥、慢性炎癥性疾病及白血病等病理過程密切相關。本抗體經ELISA和免疫組化(IHC)嚴格驗證,在IHC應用中推薦使用1:50-1:200稀釋度,可清晰檢測組織樣本中CSF3R蛋白的定位與表達水平,實驗數據顯示其具有高靈敏度和低交叉反應性。該產品適用于中性粒細胞發育機制研究、炎癥相關疾病模型分析以及血液系統腫瘤的體外實驗,為探索CSF3R信號通路調控、藥物靶點篩選及病理模型構建提供高效工具。通過基因重組技術制備,本抗體具備優異的批次間一致性和穩定性,可滿足復雜實驗體系對重復性的高標準要求,適用于細胞染色、蛋白互作分析及功能性研究等多元化科研場景。
-
Uniprot No.:
-
基因名:
-
別名:CD 114 antibody; CD114 antibody; CD114 antigen antibody; Colony stimulating factor 3 receptor (granulocyte) antibody; Colony stimulating factor 3 receptor antibody; CSF 3R antibody; CSF3R antibody; CSF3R_HUMAN antibody; Csfgr antibody; G CSF R antibody; G-CSF receptor antibody; G-CSF-R antibody; GCSFR antibody; Granulocyte colony stimulating factor receptor antibody; Granulocyte colony-stimulating factor receptor antibody; OTTHUMP00000009703 antibody; OTTHUMP00000009704 antibody; OTTHUMP00000009705 antibody
-
反應種屬:Human
-
免疫原:Recombinant Human CSF3R protein
-
免疫原種屬:Homo sapiens (Human)
-
標記方式:Non-conjugated
-
克隆類型:Monoclonal
-
抗體亞型:hIgG1
-
純化方式:Affinity-chromatography
-
克隆號:11C11
-
濃度:It differs from different batches. Please contact us to confirm it.
-
保存緩沖液:Preservative: 0.03% Proclin 300
Constituents: 50% Glycerol, 0.01M PBS, PH 7.4 -
產品提供形式:Liquid
-
應用范圍:ELISA, IHC
-
推薦稀釋比:
Application Recommended Dilution IHC 1:50-1:200 -
Protocols:
-
儲存條件:Upon receipt, store at -20°C or -80°C. Avoid repeated freeze.
-
貨期:Basically, we can dispatch the products out in 1-3 working days after receiving your orders. Delivery time maybe differs from different purchasing way or location, please kindly consult your local distributors for specific delivery time.
-
用途:For Research Use Only. Not for use in diagnostic or therapeutic procedures.
相關產品
靶點詳情
-
功能:Receptor for granulocyte colony-stimulating factor (CSF3), essential for granulocytic maturation. Plays a crucial role in the proliferation, differientation and survival of cells along the neutrophilic lineage. In addition it may function in some adhesion or recognition events at the cell surface.
-
基因功能參考文獻:
- Expression and role of granulocyte macrophage colony-stimulating factor receptor (GM-CSFR) and granulocyte colony-stimulating factor receptor (G-CSFR) on Ph-positive acute B lymphoblastic leukemia. PMID: 29338593
- we report here for the first time changes in the allele frequencies of CSF3R-T618I and SETBP1-G870S with response to ruxolitnib as well as insights into the clonal evolution of CNL under selective pressure from ruxolitinib. PMID: 28209656
- CSF3R genetic polymorphism occurred more frequently in the individuals with Septic Arthroplasty failure - Periprosthetic Joint Infection. PMID: 29305046
- G-CSF-R is C-mannosylated at W318 and that this C-mannosylation has role(s) for myeloid cell differentiation through regulating downstream signaling. PMID: 29501745
- CSF3R mutations co-occur with CEBPA mutations in pediatric acute myeloid leukemia. PMID: 27143256
- we have expanded the region of the CSF3R cytoplasmic domain in which truncation or missense mutations exhibit leukemogenic capacity, which will be useful for evaluating the relevance of CSF3R mutations in patients and helpful in defining targeted therapy strategies. PMID: 28439110
- our data demonstrates that E6AP facilitates ubiquitination and subsequent degradation of G-CSFR leading to attenuation of its downstream signaling and inhibition of granulocytic differentiation. PMID: 28578910
- study aimed to identity and characterize novel CSF3R extracellular missense mutations from exome sequencing of leukemia patients; results show the structural and functional importance of conserved extracellular cysteine pairs in CSF3R PMID: 28652245
- a central role of enhanced Mapk signaling in CSF3R-induced leukemia. PMID: 28031554
- CSF3R T618I mutation is associated with Chronic neutrophilic leukemia. PMID: 28209919
- biallelic CSF3R mutations were identified In the group of congenital neutropenia patients; CSF3R mutant clones are highly dynamic and may disappear and reappear during continuous granulocyte colony-stimulating factor (G-CSF) therapy. The time between the first detection of CSF3R mutations and overt leukemia is highly variable PMID: 27270496
- Co-occurrence of mutations in CSF3R and CEBPA in a well-defined AML subset, which uniformly responds to JAK inhibitors; this paves the way to personalized clinical trials for this disease. PMID: 27034432
- The quantitative methods used in this study have shown non-altered expression levels of different microglial markers (Iba-1, Cd11b and CD68), together with increased expression of IL6, IL10RA, colony stimulating factor 3 receptor and toll-like receptor 7 in the thalamus in FFI, which explains the seemingly contradictory results of the previous studies. PMID: 27056979
- This study proposes that acquisition of CSF3R mutations may represent a mechanism by which myeloid precursor cells carrying the ELANE mutations evade the proapoptotic activity of the Neutrophil Elastase mutants in SCN patients. PMID: 28073911
- CSF3R expression is significantly upregulated in human masticatory mucosa during wound healing PMID: 28005267
- Results indicate that granulocyte-colony stimulating factor receptor, tissue factor, and vascular endothelial growth factor receptor bound vascular endothelial growth factor expression as well as their co-expression might influence breast cancer biology. PMID: 27629739
- The Colony-Stimulating Factor 3 Receptor T640N Mutation Is Oncogenic, Sensitive to JAK Inhibition, and Mimics T618I PMID: 26475333
- CSF3R mutations, mechanisms of mutations, and their contributions to the myeloid malignancies (Review) PMID: 26956865
- In conclusion, rhCSF3 can promote melanocyte proliferation through CSF3R without affecting tyrosinase activity PMID: 25666388
- CSF3R mutations are associated with congenital neutropenia. PMID: 26324699
- The leukemogenic potential of G-CSFRIV is associated with the Stat5-dependent dysregulation of miR-155 and the target genes of this miRNA. PMID: 25730818
- No CSF3R mutations were found in cases of MDS, JMML or ET. The only mutation found in the CALR gene was a frameshift (p.L367 fs) in one ET patient. PMID: 25858548
- The SETBP1 and ASXL1 mutations have pathogenetic roles in CSF3R-mutated chronic neutrophilic leukemia. PMID: 25850813
- CSF3R polymorphisms are associated with chronic neutrophilic leukemia. PMID: 25708716
- CSF3R T618I mutation as a disease-specific marker of atypical CML post allo-SCT in two patients. PMID: 24614839
- the incorporation of CSF3R mutation testing can be a useful point-of-care diagnostic to evaluate the presence of a clonal myeloid disorder, as well as providing the potential for genetically informed therapy. PMID: 25533830
- study to see if the CSF3R p.T618I mutation was present in acute myelogenous leukemia (AML) and solid tumors of Korean patients; data revealed that CSF3R p.T618I mutation occurred in an AML with myelodysplasia-related changes and a refractory anemia with excess blasts in transformation PMID: 25404019
- A de novo CSF3R mutation was associated with the transformation of myeloproliferative neoplasm to atypical chronic myeloproliferative leukemia. PMID: 25865944
- mutation analysis of CSF3R, SETBP1 and CALR should be included in the diagnostic criteria for chronic neutrophilic leukemia PMID: 25316523
- The expression of G-CSFR before preoperative irradiation may predict the radiosensitivity of rectal cancer. PMID: 24574781
- this study describes a novel genetic Severe congenital neutropenia type in 2 unrelated families associated with recessively inherited loss-of-function mutations in CSF3R, encoding the granulocyte colony-stimulating factor (G-CSF) receptor. PMID: 24753537
- concurrent CSF3R and SETBP1 mutations are associated with Chronic neutrophilic leukemia. PMID: 24445868
- frequency of CSF3R mutations is highly prevalent among acute myeloid leukemia patients secondary to severe congenital neutropenia compared to de novo AML. PMID: 24746896
- The detection of both RUNX1 and CSF3R mutations could be used as a marker for identifying Congenital neutropenia patients with a high risk of progressing to leukemia or myelodysplastic syndromes. PMID: 24523240
- Thr-615 and Thr-618 sites of membrane-proximal mutations are part of an O-linked glycosylation cluster. Mutation at these sites prevents O-glycosylation of CSF3R and increases receptor dimerization. PMID: 24403076
- Fbw7 together with GSK3beta negatively regulates G-CSFR expression and its downstream signaling. PMID: 23820376
- Mice transplanted with human CSF3R T618I-expressing hematopoietic cells developed a myeloproliferative disorder characterized by overproduction of granulocytes and granulocytic infiltration of the spleen and liver, which was uniformly fatal. PMID: 24081659
- The stimulating factor 3 receptor mutation (CSF3R-T595I) found in acute myeloid leukemia patients was found to have ligand independent activation properties. PMID: 23508011
- findings show CSF3R somatic mutations can be identified in 4 percent of the patients with chronic myelomonocytic leukemia (CMML); these mutations, which affect distinct residues in CSF3R are frequently associated with mutations in ASXL1 gene and have a poor prognostic impact on overall and AML-free survival PMID: 23774674
- In myelodysplastic syndromes, altered CD114 distribution was more informative than density changes. In CML, CD114 density was significantly decreased on early blasts and expression was essentially limited to late blasts. PMID: 23897249
- A subpopulation of GCSFR positive neuroblastoma cells exhibit enhanced tumorigenicity and a stem cell phenotype. PMID: 23687340
- Certain missense single nucleotide polymorphisms, especially which are placed in the conserved regions of G-CSFR may possess the capacity to influence the response to G-CSF treatment. PMID: 23159284
- Mutations in CSF3R are common in patients with CNL or atypical CML and represent a potentially useful criterion for diagnosing these neoplasms. PMID: 23656643
- CSF3R gene polymorphism plays a significant role in hematopoietic stem and progenitor cells for transplantation. PMID: 22796466
- An acquired CSF3R mutation in an adult chronic idiopathic neutropenia patient who developed acute myeloid leukaemia. PMID: 22146088
- Pretreatment of PMNs with IFN-gamma or G-CSF for a long-time (22 h)induced a significant lower fungal damage against biofilms compared with planktonic cells. PMID: 21641233
- Gemcitabine can enhance in vitro the expression rate of bone marrow G-CSFR in chronic myeloid leukemia patients at chronic or blastic phases. PMID: 21129254
- Two cases of X-linked neutropenia are reported that evolved to acute myeloid leukemia or myelodysplasia, with acquisition of G-CSF receptor mutations. PMID: 19794089
- There was no significant difference in expression rate of G-CSFR on CD34+ cells between aplastic anemia, myelodysplastic syndrome, and controls. PMID: 19099633
- CD123+CD34+CD38- cells exhibited lower expression of G-CSF receptors, which might partly explain why MDS clone responds worse to G-CSF in vitro and in vivo. PMID: 20819538
顯示更多
收起更多
-
相關疾病:Hereditary neutrophilia (NEUTROPHILIA); Neutropenia, severe congenital 7, autosomal recessive (SCN7)
-
亞細胞定位:[Isoform 2]: Secreted.; Cell membrane; Single-pass type I membrane protein.
-
蛋白家族:Type I cytokine receptor family, Type 2 subfamily
-
組織特異性:One or several isoforms have been found in myelogenous leukemia cell line KG-1, leukemia U-937 cell line, in bone marrow cells, placenta, and peripheral blood granulocytes. Isoform GCSFR-2 is found only in leukemia U-937 cells. Isoform GCSFR-3 is highly e
-
數據庫鏈接:
Most popular with customers
-
-
YWHAB Recombinant Monoclonal Antibody
Applications: ELISA, WB, IHC, IF, FC
Species Reactivity: Human, Mouse, Rat
-
Phospho-YAP1 (S127) Recombinant Monoclonal Antibody
Applications: ELISA, WB, IHC
Species Reactivity: Human
-
-
-
-
-